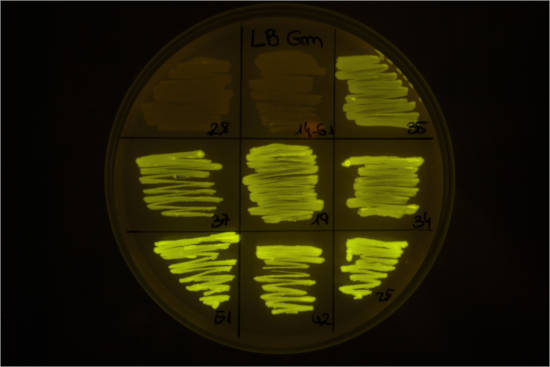

Un equipo de investigación del Consejo Superior de Investigaciones Científicas (CSIC), organismo adscrito al Ministerio de Ciencia, Innovación y Universidades, ha conseguido identificar las dinámicas de los circuitos genéticos de Pseudomonas protegens, una bacteria presente en el suelo con propiedades medioambientales únicas en el control biológico de patógenos vegetales. Este conocimiento es clave para lograr la utilización de esta especie bacteriana como herramienta biotecnológica en ecosistemas de suelos, lo que se conoce como su domesticación. Los resultados, publicados en Cell Systems, han sido obtenidos en el Laboratorio de Biocomputación del Centro Nacional de Biotecnología (CNB-CSIC) mediante técnicas de computación viva, una metodología transdisciplinar que programa bacterias desde una lógica computacional.
La base de la biología sintética es la modificación de microorganismos naturales para conseguir funciones celulares nuevas con aplicaciones biotecnológicas como la degradación de compuestos tóxicos o la producción de compuestos con usos industriales. Aunque habitualmente se utilizan bacterias “modelo” que crecen fácilmente en condiciones de laboratorio, es fundamental poder utilizar las bacterias que crecen en los lugares concretos en los que se quiere implementar su uso. El trabajo dirigido por Ángel Goñi-Moreno, investigador del CSIC en el CNB y con la participación del Centro de Biotecnología y Genómica de Plantas, detalla el proceso de domesticación de P. protegens y el funcionamiento de los circuitos genéticos en esta especie.
Escherichia coli es una de las bacterias más utilizadas como herramienta en biología sintética por el amplio conocimiento del funcionamiento de los sistemas de regulación génica. Otras especies bacterianas como Bacillus subtilis o Pseudomonas putida también se están domesticando con éxito. Sin embargo, “la comparación de los datos de distintas especies muestra que no se puede extrapolar lo aprendido en una especie a las demás, el contexto celular de cada especie es importante para el funcionamiento de un gen concreto” explica Goñi-Moreno. “Una misma secuencia genética se comporta de distinta manera en función de la presencia de distintos elementos reguladores en cada especie, de ahí la necesidad de probar su funcionamiento en cada especie, y poder aprovechar esta especificidad, que puede proporcionar ventajas en diversos ámbitos de aplicación”, añade.
P protegens es un microorganismo típico del suelo con un metabolismo extremadamente versátil, y que puede aislarse de raíces de varias especies de plantas. Esta especie tiene un alto valor medioambiental, ya que produce compuestos activos contra diversos patógenos de las plantas. Además de proteger eficazmente las raíces de las plantas contra hongos fitopatógenos, también es tóxica para algunos insectos. De ahí el interés del equipo por domesticar esta especie. Utilizando una biblioteca de circuitos de regulación genética conocidos en otras bacterias, los investigadores han logrado caracterizar su comportamiento en P. protegens.
“A partir de datos del funcionamiento de distintas redes en distintos organismos y del uso de modelos matemáticos complejos, hemos llegado a predecir el comportamiento de nuevas redes y de genes que insertamos en el sistema,” señala Pablo Japón, investigador del CSIC en el CNB. Por su parte, Juan Rico, también investigador del CSIC en el CNB detalla: “Nuestro trabajo en investigación básica está permitiendo desarrollar nuevas herramientas que actúan como ‘chasis’ para aplicaciones medioambientales, como la producción de compuestos o la biorremediación”.
Lógica computacional con material vivo
La computación clásica buscaba la manera de procesar información y convertirla en otra distinta. Con esa base tecnológica se han construido ordenadores capaces de realizar operaciones lógicas basándose en chips de silicio, pero ese tipo de sustrato no es el único posible para la computación. El laboratorio de Biocomputación dirigido por Ángel Goñi-Moreno tiene como objetivo la utilización de material vivo, bacterias, para procesar información biológica, ya que el ADN es un sistema de almacenamiento de información que se puede utilizar para procesar información y generar una respuesta en el entorno.
A la pregunta de cómo se utiliza una bacteria para hacer computación, Goñi-Moreno explica: “No se trata de enviar un correo electrónico con una bacteria”. Los ordenadores convencionales no pueden usar de manera fiable información probabilística, los cuánticos sí, pero son de difícil manejo. En cambio, las redes de regulación génica manejan información probabilística de manera natural, a temperatura ambiente y de forma más optima que la tecnología convencional de silicio. Solo hay que pensar en qué tipo de procesos de información son adecuados para usar sustratos biológicos y un claro ejemplo es el medio ambiente”.
“Por ejemplo, pensemos en utilizar la temperatura como información, la capturas con un termostato conectado a un ordenador y regulas la temperatura de una habitación. En un microorganismo, se puede producir una proteína sensible al calor, al alcanzar el entorno una temperatura X, esa proteína actúa como interruptor o señal para activar la producción de un compuesto concreto que te dice el cambio de temperatura que ha ocurrido y en que circunstancia”, añade el investigador. Los resultados de este trabajo mejoran las posibilidades de aplicación de este “chasis” bacteriano poco convencional en ecosistemas ambientales.





Política de comentarios:
Tenemos tolerancia cero con el spam y con los comportamientos inapropiados. Agrodigital se reserva el derecho de eliminar sin previo aviso aquellos comentarios que no cumplan las normas que rigen esta sección.